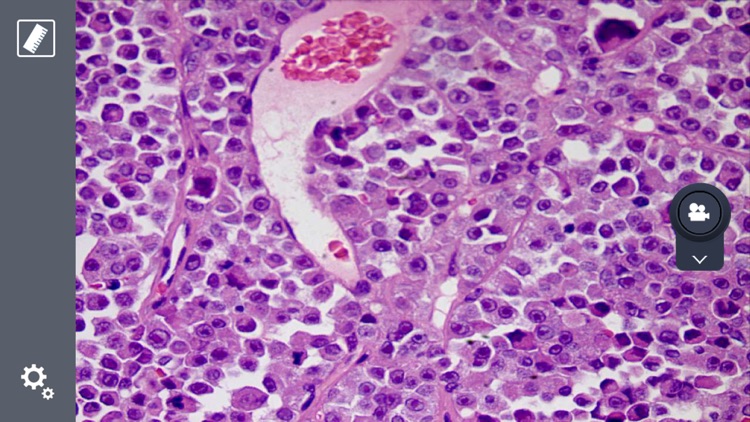
HotSpotView

You are using an outdated browser. Please
upgrade your browser to improve your experience.

HotSpotView通过WIFI热点传输,可实现共享显微镜画面功能,实现动态预览,可以在预览图上进行标记,可以拍照到本地也可以进行视频录制,可以定制需要采集的热点服务器IP,依次来切换不同的显微镜画面。

HotSpotView
by Sunny Group Co., Ltd.



What is it about?
HotSpotView通过WIFI热点传输,可实现共享显微镜画面功能,实现动态预览,可以在预览图上进行标记,可以拍照到本地也可以进行视频录制,可以定制需要采集的热点服务器IP,依次来切换不同的显微镜画面。

App Screenshots

App Store Description
HotSpotView通过WIFI热点传输,可实现共享显微镜画面功能,实现动态预览,可以在预览图上进行标记,可以拍照到本地也可以进行视频录制,可以定制需要采集的热点服务器IP,依次来切换不同的显微镜画面。
【实时预览】
通过WIFI实现连接,可获取共享显微镜最高实时显示1080P画面效果
【画面标记】
可以实现在预览画面上进行标记的功能,具体标记为点,直线,矩形,圆,同心圆,圆心距,十字线,垂直线,角度,文字, 单个删除,全部删除,可实现实时的添加删除标记,可定义标记文字的不同颜色
【画面存储】
可以实现拍照到本地,把预览到的画面保存到本地,可以把标记同时保存到图像,实现对预览画面进行视频录制,通过调用自带相册查看,可以对存储的照片、视频进行查看
Disclaimer:
AppAdvice does not own this application and only provides images and links contained in the iTunes Search API, to help our users find the best apps to download. If you are the developer of this app and would like your information removed, please send a request to takedown@appadvice.com and your information will be removed.
AppAdvice does not own this application and only provides images and links contained in the iTunes Search API, to help our users find the best apps to download. If you are the developer of this app and would like your information removed, please send a request to takedown@appadvice.com and your information will be removed.